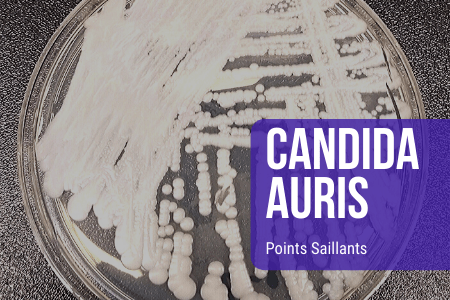

Vous me connaissez : j’ai déjà consacré plusieurs articles aux organismes qui s’invitent dans notre corps sans y avoir été conviés, des parasites intestinaux aux levures invasives. Décidément, le monde des « bestioles envahissantes » ne manque pas de candidats. Aujourd’hui, c’est un champignon qui retient mon attention. Et celui-ci cumule des caractéristiques qui méritent aussi qu’on en parle sérieusement.
Entre 29 et 62% de mortalité. C’est ce que documente le Centre européen de prévention et de contrôle des maladies (ECDC) dans son enquête publiée en septembre 2025 sur Candidozyma auris, anciennement connu sous le nom de Candida auris, qu’il classe en « priorité critique » mondiale. Et pourtant, vous n’en avez probablement jamais entendu parler.
Un pathogène identifié en 2009, déjà endémique dans plusieurs pays
Identifié pour la première fois en 2009 chez un patient japonais, Candida auris s’est propagé à une vitesse qui surprend encore les épidémiologistes. Des 4 012 cas recensés dans l’Union européenne entre 2013 et 2023, plus de la moitié ont été déclarés lors des deux seules années 2022 et 2023 (CIDRAP, septembre 2025).
Les cinq pays les plus touchés sont l’Espagne, la Grèce, l’Italie, la Roumanie et l’Allemagne. Dans quatre d’entre eux, il n’est plus possible de distinguer des foyers épidémiques distincts : l’infection est désormais endémique à l’échelle régionale (CIDRAP, septembre 2025).
La France n’est pas épargnée. Depuis janvier 2023, 31 cas ont été signalés, dont 13 rien qu’en 2025, avec un cluster en cours (RÉPIA / Prévention Infection, mai 2025). Un épisode particulièrement préoccupant avait déjà eu lieu en Ile-de-France en 2022 : 38 cas dans un seul établissement, sur 6 services, avec comme cas index un rapatriement sanitaire depuis le Koweït (CPIAS Centre, juillet 2025).
Ces chiffres ne reflètent qu’une fraction de la réalité : la surveillance systématique n’est pas encore en place dans la majorité des pays européens, et de nombreux foyers restent non détectés (ECDC, septembre 2025).
Ce qui rend Candida auris particulièrement redoutable
Une résistance aux traitements hors norme. La majorité des souches sont résistantes au fluconazole, l’antifongique le plus couramment prescrit. Les échinocandines constituent le traitement de deuxième ligne, mais des souches résistantes à toutes les classes d’antifongiques disponibles ont déjà été signalées (CIDRAP, septembre 2025).
Une persistance environnementale hors du commun. Le champignon colonise la peau des patients et se transmet facilement dans les services hospitaliers, depuis les rails de lit jusqu’aux rideaux, en passant par les sols et les équipements médicaux. Les désinfectants standard ne parviennent pas à l’éliminer (CIDRAP, septembre 2025).
Une vitesse de colonisation alarmante. En Espagne, en Grèce, en Italie et en Roumanie, le délai entre le premier cas documenté et une endémie régionale n’a été que de cinq à sept ans (CIDRAP, septembre 2025).
Un diagnostic difficile. Les symptômes ne forment pas un tableau clinique uniforme et sont facilement confondus avec d’autres infections, ce qui retarde la détection des foyers (De Gaetano S. et al., Microorganisms/MDPI, mai 2024).
Des symptômes trompeurs, une issue parfois fatale
Candida auris débute souvent comme un simple état grippal, sans signe d’alarme évident. Fièvre, frissons, courbatures : rien qui ne permette de suspecter un champignon multirésistant. Le problème, c’est que chez les personnes fragilisées (personnes âgées, immunodéprimées, diabétiques, grands prématurés, patients en réanimation), les taux de mortalité documentés oscillent entre 29 et 62% (ECDC, septembre 2025). Une revue de littérature couvrant 2009-2025, publiée début 2026 dans Clinical Microbiology and Infection, confirme une mortalité moyenne de 30% pour les candidémies (ScienceDirect, janvier 2026).
Aux Etats-Unis et dans le monde : une accélération inquiétante
L’Europe n’est pas seule concernée. Le CDC américain (Centers for Disease Control and Prevention) a recensé 6 304 cas cliniques en 2024, contre 4 514 en 2023 (CDC américain, mis à jour 2025). En 2025, ce chiffre aurait dépassé les 7 000 cas aux seuls Etats-Unis, et le champignon a désormais été identifié dans au moins 60 pays (Rajendran R. et al., Microorganisms/MDPI, mars 2025).
Ce que la naturopathie en dit
Candida auris frappe presque exclusivement des organismes déjà fragilisés : personnes immunodéprimées, patients sous traitements lourds, microbiotes appauvris par des années d’antibiotiques.
En naturopathie, nous partons d’un principe simple : un terrain solide est la meilleure protection qui soit. Cela ne signifie pas qu’un corps en bonne santé est invulnérable à tout pathogène, mais qu’il dispose de bien meilleures ressources pour résister.
Concrètement, entretenir ce terrain, c’est prendre soin de son microbiote intestinal (qui représente environ 70% de notre immunité), limiter les agressions répétées (antibiotiques non indispensables, alimentation ultra-transformée, stress chronique), et soutenir les organes émonctoires qui filtrent et éliminent les déchets de l’organisme.
Face à des champignons de type levure comme Candida albicans, dont Candida auris est un cousin beaucoup plus agressif, la naturopathie propose des approches complémentaires : rééquilibrage de la flore, soutien immunitaire, accompagnement du terrain. Pas pour remplacer la médecine quand l’urgence est là, mais pour ne pas lui laisser tout le travail.

Ce que cela révèle sur nos défenses naturelles
Candida auris ne s’installe pas dans n’importe quel organisme. Il profite d’un terrain fragilisé : traitements antibiotiques répétés, système immunitaire affaibli, déséquilibre du microbiote. Il cible en priorité les patients en réanimation et les unités à haut risque, là où les défenses de l’organisme sont au plus bas (Rajendran R. et al., Microorganisms/MDPI, mars 2025).
C’est précisément pour cette raison que l’entretien du terrain me semble plus pertinent que jamais. Non pas comme alternative à la médecine d’urgence quand l’infection est déclarée, mais comme démarche préventive quotidienne : soutenir l’immunité, équilibrer la flore intestinale, renforcer les barrières naturelles de l’organisme.
C’est dans cette logique que j’ai conçu le protocole ImmunoPur, une approche naturelle axée sur l’accompagnement du terrain, le rééquilibrage de la flore et le soutien des défenses immunitaires face aux parasites et champignons de type levure, dont le Candida albicans. Si le sujet vous parle, le protocole est en lien ci-dessous.
Sources
- ECDC, Survey on the epidemiological situation, laboratory capacity and preparedness for Candidozyma auris, septembre 2025 : ecdc.europa.eu
- ECDC, communiqué Drug-resistant fungus Candidozyma auris confirmed to spread rapidly in European hospitals, septembre 2025 : ecdc.europa.eu
- CIDRAP, Multidrug-resistant yeast cases rising rapidly in Europe, septembre 2025 : cidrap.umn.edu
- RÉPIA / Prévention Infection, données France, mai 2025 : prevention-infection.fr
- CPIAS Centre, retour d’expérience cluster Ile-de-France, juillet 2025 : cpias-centre.fr
- De Gaetano S. et al., Candida auris Outbreaks: Current Status and Future Perspectives, Microorganisms/MDPI, mai 2024 : pmc.ncbi.nlm.nih.gov
- Candidozyma auris: resistant, long lasting, and everywhere, Clinical Microbiology and Infection, ScienceDirect, janvier 2026 : sciencedirect.com
- CDC américain (Centers for Disease Control and Prevention), Tracking Candida auris, mise à jour de 2025 : cdc.gov
- Rajendran R. et al., Candida auris: A Continuing Threat, Microorganisms/MDPI, mars 2025 : mdpi.com
Article rédigé à titre informatif. En cas de symptômes ou de doute, consultez un professionnel de santé.
Anna Scheele ©Technosphere
✅ Accès immédiat à tous mes contenus exclusifs
✅ Canal Telegram privé
✅ Consultation FLASH incluse
✅ Protocole offert pour l’abonnement annuel ✨

